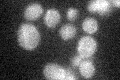
YBR229C
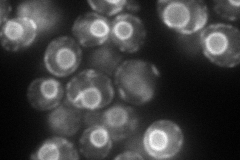
YBR229C

View description
Glucosidase II catalytic subunit required for normal cell wall synthesis; mutations in rot2 suppress tor2 mutations, and are synthetically lethal with rot1 mutations
Localization:
Intensity:
Fold change:
Significance:
-
C’ GFP library in SD
below threshold18.34 -
N' NOP1pr-GFP in SD
ER121.497 -
N' TEF2pr-mCherry in SD

ER73.7337 -
N' NATIVEpr-GFP in SD

ER36.5736 -
N' TEF2pr-VC and Cyto-VN in SD

#N/A0 -
C’ GFP library in SD+DTT

cytosol12.610.68No -
C’ GFP library in SD+H2O2

cytosol15.150.82No -
C’ GFP library in Starvation Media

cytosol15.610.85No -
C’ GFP library on the background of Pup2-DaMP

below threshold -
C’ GFP library on the background of CCT mutant

below threshold15.3410.836144No
